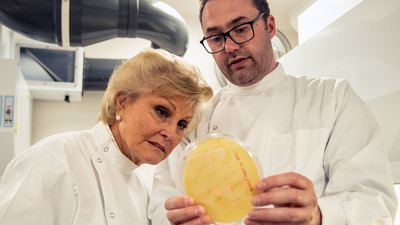

Kate Pringle
Director

The Truth About... (2015)
Series 1
Science documentary series tackling everyday issues that affect us all. Each episode features different presenters and experts in their fields.
Released March 19, 2015
Episode 60 min
None+
Genres: Documentary, Talk
Keywords: tmdb.health-care, imdb.science
Network: BBC One
Country: United Kingdom
Languages:
English
S1E1 - Sugar
Journalist Fiona Phillips is on a mission to find out the truth behind the recent headlines on sugar.
March 19, 2015, midnight
S1E2 - Calories
Dr Chris van Tulleken investigates Britain's favourite foods to discover the truth about calories and shows how we can all be healthier by eating smarter.
March 26, 2015, midnight
S1E3 - Fat
Dr Saleyha Ahsan cuts through the confusion and reveals the surprising science of fat - which types of fat we should be eating, and how much is good for us.
April 2, 2015, midnight
S1E4 - Your Medicine Cabinet
Dr Chris Van Tulleken calls on the British public to seek out the truth about the top-selling over-the-counter medicines.
April 9, 2015, midnight
S1E5 - Your Teeth - Part 1
Britain's top dentists show how the latest science can change how we all look after our teeth.
June 4, 2015, midnight
S1E6 - Your Teeth - Part 2
The mission continues to change the way we all look after our gnashers.
June 11, 2015, midnight
S1E7 - Dementia
Angela Rippon investigates Alzheimer's disease. She learns how people can help to prevent it, meets some of those who are living with it and explores her own risk of developing it.
May 19, 2016, midnight
S1E8 - Alcohol
A&E doctor Javid Abdelmoneim is on a mission to find out the truth about alcohol, including why the government cut the recommended weekly limit for men by a third in January.
May 26, 2016, midnight
S1E9 - Healthy Eating
Fiona Phillips teams up with leading scientists to investigate how people can eat and drink themselves to good health.
June 2, 2016, midnight
S1E10 - Meat
Chris Bavin joins a team of scientists as they follow 40 volunteers on a groundbreaking study to find out exactly how much meat is good for people.
Sept. 29, 2016, midnight
S1E11 - Stress
Fiona Phillips explores the latest scientific research into the perception, experience and management of stress.
May 4, 2017, midnight
S1E12 - Sleep
We are one of the most sleep-deprived countries in the world. In The Truth About Sleep, insomniac Michael Mosley finds out what happens if we don't get enough sleep and looks at surprising solutions to help us get more.
May 11, 2017, midnight
S1E13 - HIV
Dr Chris van Tulleken explores the latest science around HIV, meeting health professionals, scientists, and individuals affected by it in the UK and South Africa.
May 25, 2017, midnight
S1E14 - Looking Good
Cherry Healey investigates the cosmetics industry to determine how much of what products promise is based on scientific evidence and how much is simply marketing manipulation.
Jan. 10, 2018, midnight
S1E15 - Getting Fit
Michael Mosley teams up with scientists whose latest research is turning common knowledge about fitness on its head to separate fact from fiction.
Jan. 31, 2018, midnight
S1E16 - Obesity
Chris Bavin looks at the latest scientific research on obesity and reveals how small lifestyle changes can help people maximize their chances of keeping trim.
April 26, 2018, midnight
S1E17 - Carbs
Dr Xand van Tulleken investigates whether claims about negative effects of carbohydrates on health are true and explores healthier ways to consume them.
June 6, 2018, midnight
S1E18 - The Menopause
Mariella Frostrup shares her own experience of the menopause and brings this great taboo out into the open, investigating how the latest science can explain what it is.
Nov. 26, 2018, midnight
S1E19 - Antibiotics
Angela Rippon looks into the new ways that scientists are trying to fight bacterial infections, as they try to combat antibiotic resistance.
Jan. 30, 2019, midnight
S1E20 - Takeaways
In the UK, we eat over three million takeaways per day. Journalist Nikki Fox teams up with scientists at Liverpool John Moores University to discover what this habit is doing to our health.
Feb. 27, 2020, midnight
S1E21 - Cosmetic Treatments (1)
Michael Mosley and Mehreen Baig investigate non-invasive facial procedures - and how they can go wrong.
Aug. 25, 2020, midnight
S1E22 - Cosmetic Treatments (2)
Michael Mosley and Mehreen Baig look at non-invasive procedures for the body, including fat freezing, fat heating and the growing use of anabolic steroids for body enhancement.
Aug. 27, 2020, midnight
S1E23 - Boosting Your Immune System
You can't feel it or see it. You can't take its pulse or its temperature. But out of sight and out of mind, your immune system is working to protect you from infectious bacteria, viruses, injuries and a host of other nasties. Due to the coronavirus, the health market has exploded with products promising to boost, support or supercharge our flagging natural defences. But which of these so-called miracle products, superfoods and supplements should we be spending our cash on, and which really have the science to back up their claims? Now, as Dr Ronx Ikharia finds out, new science is revealing that the human body’s most extraordinary structure – a complex fighting system powered by five litres of blood and lymph – has the capacity to be supercharged and improved if we have the science know-how to do it. This is the definitive guide, not only to defending yourself against Covid-19, but also boosting your strength for when the cold and flu season is upon us.
Jan. 6, 2021, midnight
S1E24 - Getting Fit at Home
During months of having to stay at home, millions of us have swapped the gym for our living room. The numbers doing home workouts has doubled in a year. But exactly what kind of exercise should we be doing, how much of it, and how often? Journalist and blogger Mehreen Baig used to hit the gym four times per week, but now her fitness regime has gone entirely DIY. She wants to use the latest science to make sure she is getting maximum return for her effort. With the help of former GB athlete Becky Lyne, Mehreen tries out some experimental new tech that could help us all transform our running technique, and she discovers how to choose a sports bra that can reduce painful movement by as much as 73 per cent. She investigates whether popular supplements like pre-trainers and protein shakes really work – and discovers some hidden ingredients we should all avoid. In a final experiment, she tests her own body to reveal how pursuing the perfect six-pack body shape can damage your health.
Jan. 13, 2021, midnight
S1E25 - Improving Your Mental Health
Clinical psychologist Professor Tanya Byron teams up with former England footballer Alex Scott, who has suffered from depression, to discover how the latest science can help us gain greater control over our state of mind and improve our mental health and wellbeing. Even in normal times, one in four of us will experience mental health difficulties, but living through a global pandemic has put our mental health under unprecedented strain. Over the past year, a team from Imperial College London, in collaboration with the BBC, have surveyed the mental health of over 350,000 people across the UK. This unique study provides a snapshot before and during the pandemic, revealing its shocking impact.
Jan. 20, 2021, midnight
BBC One
60 min/ep
60 min
March 19, 2015
Jan. 20, 2021, midnight
Returning Series
NR
Action
Action
Rate this show
Add {Movie} to static lists